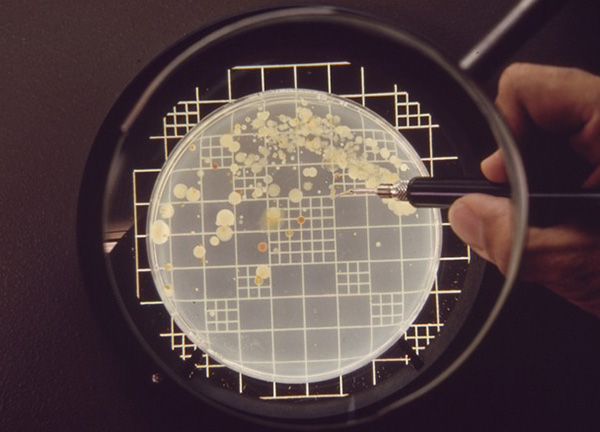
Có 03 phương pháp xác định CFU phổ biến trong kiểm nghiệm vi sinh

CFU là chỉ số quan trọng trong kiểm nghiệm vi sinh, dùng để định lượng số vi sinh vật sống có khả năng phát triển trong mẫu thử. Vậy cụ thể CFU là gì? Tại sao chỉ số này lại quan trọng đến vậy trong việc xác định độ an toàn của thực phẩm và sức khỏe đường ruột? MT sẽ giải đáp chi tiết trong bài viết sau đây.

CFU là gì?
CFU là viết tắt của cụm từ tiếng Anh Colony Forming Unit, dịch sang tiếng Việt là Đơn vị hình thành khuẩn lạc.
Trong nuôi cấy vi sinh, CFU được hiểu đơn giản là một đơn vị dùng để ước tính số lượng các tế bào vi khuẩn hoặc nấm khả thi trong một mẫu thử nghiệm. “Khả thi” ở đây nghĩa là tế bào đó còn sống và có khả năng phân chia để tạo thành một khuẩn lạc nhìn thấy được bằng mắt thường trên môi trường thạch.

Vì sao phải xác định CFU?
Hiểu được CFU là gì là bước đầu, nhưng hiểu được tầm quan trọng của nó mới giúp bạn ứng dụng hiệu quả trong công việc. Việc xác định chỉ số CFU đóng vai trò cốt lõi trong nhiều lĩnh vực:
Đánh giá vệ sinh an toàn thực phẩm và nước uống
Đây là ứng dụng phổ biến nhất. Các cơ quan quản lý (như Bộ Y tế, FDA) luôn đưa ra các tiêu chuẩn giới hạn về CFU là gì trong thực phẩm.
Ví dụ: Trong nước uống đóng chai, chỉ số E. coli phải là 0 CFU/250mL. Nếu kết quả xét nghiệm cho thấy có sự xuất hiện của khuẩn lạc, lô hàng đó sẽ bị coi là không an toàn. Việc đếm CFU giúp phát hiện nguy cơ nhiễm khuẩn, bảo vệ sức khỏe cộng đồng.

Kiểm định chất lượng Probiotic (Men vi sinh)
Với những người quan tâm đến sức khỏe đường ruột, chỉ số CFU trong probiotic là thước đo chất lượng.
- Một sản phẩm men vi sinh tốt thường cam kết chứa hàng tỷ lợi khuẩn (ví dụ: 10^ 9 CFU).
- Con số này cho biết lượng vi khuẩn còn sống khi đến tay người dùng. Nếu chỉ số CFU quá thấp, sản phẩm sẽ không mang lại tác dụng cân bằng hệ vi sinh đường ruột như mong đợi.

Đánh giá hiệu quả của quy trình tiệt trùng và kháng sinh
Trong y tế và dược phẩm, xác định CFU giúp các nhà nghiên cứu biết được thuốc kháng sinh có hiệu quả diệt khuẩn hay không, hoặc quy trình tiệt trùng dụng cụ y tế đã đạt chuẩn vô trùng hay chưa.
So sánh với các phương pháp khác (như MPN)
Đôi khi người học sẽ thắc mắc sự khác biệt giữa MPN và CFU là gì. Trong khi MPN (Most Probable Number) là phương pháp thống kê xác suất thường dùng cho mẫu có mật độ vi sinh thấp hoặc nhiều cặn bẩn, thì CFU là phương pháp đếm trực tiếp khuẩn lạc, cho độ chính xác cao hơn ở các mẫu có mật độ vi sinh vật cao và dễ nuôi cấy.
Công thức tính CFU trong kiểm nghiệm vi sinh
Việc nắm vững công thức tính là bước quan trọng nhất sau khi hiểu CFU là gì.
Công thức tính tổng quát
| CFU/mL(hoặc CFU/g)=(N×D)/V |
Trong đó:
- N: Số lượng khuẩn lạc đếm được trên đĩa (thường chọn đĩa có từ 30 – 300 khuẩn lạc để đảm bảo độ tin cậy thống kê).
- D: Hệ số pha loãng. (Ví dụ: Nếu pha loãng 10 ^− 3 , thì hệ số D là 10^3 hay 1.000).
- V: Thể tích mẫu cấy vào đĩa (mL).
Ví dụ minh họa
Bạn tiến hành kiểm tra vi sinh trong nước. Bạn pha loãng mẫu nồng độ 10^4. Bạn hút 0.1 mL dịch pha loãng này trải lên đĩa thạch. Sau thời gian ủ, ghi nhận được 45 khuẩn lạc.
Cách tính:
- N = 45
- Hệ số pha loãng (nghịch đảo của 10^−4 )= 10^4
- V = 0.1 mL
➤ CFU/mL= (45×10.000)/0.1=4,500,000=4.5×10^6 CFU/mL
Ứng dụng của chỉ số CFU
Việc hiểu CFU là gì giúp áp dụng chỉ số này vào rất nhiều lĩnh vực quan trọng:
- Kiểm nghiệm thực phẩm và đồ uống: Các cơ quan quản lý (như Bộ Y tế) quy định giới hạn CFU cho phép đối với vi khuẩn hiếu khí, nấm men và nấm mốc trong thực phẩm. Ví dụ: Sữa tươi tiệt trùng phải có chỉ số CFU cực thấp để đảm bảo không bị hư hỏng.
- Xử lý nước và nước thải: Chỉ số CFU của E. coli hoặc Coliform là tiêu chuẩn vàng để xác định nước có bị ô nhiễm phân hay không, có an toàn để uống hoặc xả thải ra môi trường không.
- Sản xuất Probiotic (Men vi sinh): Trên bao bì các loại men vi sinh hay sữa chua, bạn thường thấy ghi “Chứa 1 tỷ lợi khuẩn (10^9 CFU)”. CFU trong probiotic đảm bảo rằng sản phẩm cung cấp đủ lượng vi khuẩn sống để mang lại lợi ích cho sức khỏe đường ruột khi đến tay người tiêu dùng.
- Sản xuất dược phẩm: Kiểm tra độ vô trùng của thuốc và các thiết bị y tế.

Các phương pháp xác định CFU phổ biến
Để đếm được CFU, các kỹ thuật viên phòng thí nghiệm thường sử dụng các phương pháp nuôi cấy trên môi trường thạch đặc. Dưới đây là ba phương pháp xác định phổ biến:
Phương pháp đổ đĩa (Pour Plate)
Mẫu được pha loãng, sau đó trộn đều với môi trường thạch lỏng (khoảng 45-50°C) rồi đổ vào đĩa petri.
- Ưu điểm: Vi khuẩn mọc cả trên bề mặt và sâu bên trong thạch, thích hợp cho vi khuẩn kỵ khí tùy nghi.
- Nhược điểm: Nhiệt độ thạch nóng có thể làm chết một số vi khuẩn nhạy cảm nhiệt.
Phương pháp trải đĩa (Spread Plate)
Một lượng nhỏ mẫu (khoảng 0.1 mL) được nhỏ lên bề mặt thạch đã đông, sau đó dùng que trải trang đều.
- Ưu điểm: Vi khuẩn chỉ mọc trên bề mặt, dễ quan sát hình thái khuẩn lạc; không bị ảnh hưởng bởi nhiệt độ.
- Nhược điểm: Chỉ dùng được thể tích mẫu nhỏ.
Phương pháp màng lọc (Membrane Filtration)
Dùng cho mẫu nước có mật độ vi sinh thấp. Nước được lọc qua màng lọc có kích thước lỗ nhỏ (0.45 µm) để giữ lại vi khuẩn, sau đó đặt màng lọc lên môi trường nuôi cấy.
- Ưu điểm: Độ nhạy cao, phát hiện được vi khuẩn trong thể tích mẫu lớn.
So sánh CFU và MPN
Trong kiểm tra vi sinh, ngoài CFU, bạn sẽ thường gặp chỉ số MPN (Most Probable Number). Vậy sự khác biệt giữa MPN và CFU là gì?
| Tiêu chí | Phương pháp CFU (Đếm khuẩn lạc) | Phương pháp MPN (Số có xác suất cao nhất) |
| Bản chất | Đếm trực tiếp số khuẩn lạc hình thành trên thạch rắn. | Ước tính thống kê dựa trên sự lên men/đục trong môi trường lỏng. |
| Độ chính xác | Độ chính xác cao hơn với mật độ vi sinh vật lớn. | Là phương pháp ước tính, khoảng tin cậy rộng hơn. |
| Môi trường | Sử dụng môi trường thạch (rắn). | Sử dụng môi trường canh thang (lỏng). |
| Ứng dụng | Tốt cho mẫu thực phẩm, chế phẩm sinh học, vi khuẩn hiếu khí. | Tốt cho mẫu nước thải, bùn, mẫu có nhiều cặn lơ lửng, Coliforms/E.coli. |

Địa chỉ cung cấp hệ thống lên men vi sinh uy tín
Hiểu rõ CFU là gì và các phương pháp xác định CFU là cơ sở quan trọng cho công tác kiểm soát chất lượng. Tuy nhiên, để sản xuất các chế phẩm sinh học có mật độ CFU cao như men vi sinh, vắc-xin hay chế phẩm xử lý môi trường, các đơn vị sản xuất cần đầu tư hệ thống nuôi cấy và lên men hiện đại với độ chính xác cao.
Nếu bạn đang tìm kiếm giải pháp công nghệ cho quy trình nuôi cấy vi sinh công nghiệp, Công ty TNHH Kỹ thuật và Thiết bị MT (MT) là đối tác đáng tin cậy.
MT là một trong những nhà sản xuất thiết bị xử lý sinh học hàng đầu tại Việt Nam. Chúng tôi cung cấp các hệ thống nồi lên men (bioreactor/fermenter) từ quy mô phòng thí nghiệm đến quy mô công nghiệp, hỗ trợ kiểm soát và nâng cao quá trình sinh trưởng của vi sinh vật, qua đó đảm bảo đạt mật độ CFU mong muốn với hiệu suất cao.
Với sứ mệnh “Trở thành một phần trong thành công của bạn”, MT cam kết mang đến các giải pháp xử lý chuyên sâu về công nghệ sinh học, đồng hành cùng các nhà máy, viện nghiên cứu và trường đại học trong việc nâng cao chất lượng sản phẩm vi sinh.

Qua bài viết, có thể thấy CFU là đơn vị cốt lõi trong kiểm nghiệm vi sinh, giúp định lượng chính xác số vi sinh vật sống trong mẫu thử. Để nâng cao độ tin cậy của phân tích, hệ thống lên men và nuôi cấy đạt chuẩn GMP/HACCP là yếu tố không thể thiếu. MT hiện là đơn vị uy tín cung cấp giải pháp và thiết bị lên men vi sinh hiện đại, hỗ trợ phân tích CFU chính xác và ổn định.
